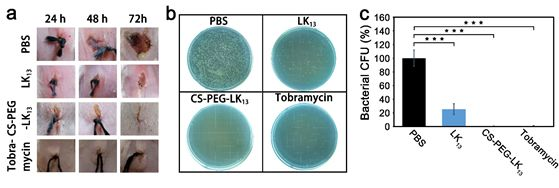

銅綠假單胞菌(P. aeruginosa)是醫院的主要威脅之一。雖然對健康人群致病力弱,但對于囊性纖維化、癌癥、燒傷等病患,銅綠假單胞菌感染可能帶來致命威脅。銅綠假單胞菌感染多以生物膜形式發生。在生物膜中,胞外高分子基質(EPS)可有效阻擋抗菌劑的滲透,使細菌對抗菌劑的耐受性提高100-1000倍。因此,如何實現抗菌劑在生物膜中的深層滲透并有效殺菌是對抗銅綠假單胞菌感染的關鍵。生物膜中富含孔徑從納米到微米不等的水合通道,且帶負電的EPS更容易吸附并阻擋帶正電的抗菌劑,因此,表面電中性、尺寸小于500nm的親水性納米粒子更容易穿透生物膜。作為一種革蘭氏陰性菌,銅綠假單胞菌的外膜由磷脂雙分子層以及帶負電的脂多糖構成,因此,兼具疏水及正電荷的分子更容易通過破壞外膜使銅綠假單胞菌失活。根據生物膜及革蘭氏陰性菌外膜的特征,理想的抗菌劑應在穿透生物膜時保持500nm以下、電中性的親水納米結構,遇到菌膜時轉變為富含正電荷和疏水域的結構。
近期,中科院理化技術研究所牛忠偉研究員課題組聯合中科院高能物理研究所陳俊副研究員,通過構建一種菌膜誘導組裝結構轉變的殼聚糖-聚乙二醇-抗菌肽偶聯物(CS-PEG-LK13)實現了抗菌劑對生物膜的深層滲透及對生物膜中細菌的有效殺滅(見圖1)

圖1 CS-PEG-LK13的組裝及抗生物膜示意圖如圖2所示,所構建的偶聯物CS-PEG-LK13在水環境中可形成直徑~100nm、外表面基本呈電中性的組裝體,帶正電的LK13肽由于被包裹在內部無法接觸膜環境而呈現無規構象。只有當遇到富含負電荷的膜結構(由POPG模擬)時,CS-PEG-LK13組裝體才會發生解組裝并暴露出兼具正電荷、疏水域、α-螺旋的LK13肽,以實現破膜殺菌。這種菌膜誘導組裝結構轉變的性質使所構建的CS-PEG-LK13偶聯物在穿透生物膜和抗菌方面都具有顯著優勢。在體外銅綠假單胞菌生物膜中,采用8倍最小抑菌濃度(MIC)時,CS-PEG-LK13的抗菌效率可達72.70%,明顯高于LK13肽(15.24%)和妥布霉素(33.57%)(圖3)。共聚焦激光掃描顯微鏡(CLSM)的成像顯示,CS-PEG-LK13組裝體可使生物膜中幾乎所有細菌失活,而LK13肽和妥布霉素僅可使生物膜中約一半細菌失活。在小鼠皮下植入生物膜感染模型中(圖4),12.5倍MIC的CS-PEG-LK13與1562倍MIC的妥布霉素表現出了相似的治療效果,兩組的小鼠傷口均愈合良好,沒有可見的炎癥,植入體上幾乎沒有剩余菌落。說明CS-PEG-LK13在對抗銅綠假單胞菌生物膜方面表現出了與大大過量的妥布霉素相當的能力。這項工作為設計針對革蘭氏陰性菌生物膜的新型抗菌劑提供了有效策略,相關研究成果以CombatingPseudomonas aeruginosa Biofilms by a Chitosan-PEG-Peptide Conjugate via Changesin Assembled Structure為題,在線發表于近期的《ACS Appl. Mater.Interfaces》。中科院理化技術研究所博士生鞠曉燕、中科院高能物理研究所陳俊副研究員為該論文的第一作者,中科院理化技術研究所牛忠偉研究員、田野副研究員是該論文的通訊作者。中科院高能物理研究所博士生周夢雪為該工作的小鼠體內驗證提供了大量實驗協助。相關研究工作得到國家重點研發計劃、國家自然科學基金、北京市自然科學基金、中科院青年創新促進會、理化所所長基金、中國科學院納米生物效應與安全性重點實驗室開放基金的大力支持。
https://pubs.acs.org/doi/10.1021/acsami.0c02034來源:高分子科學前沿